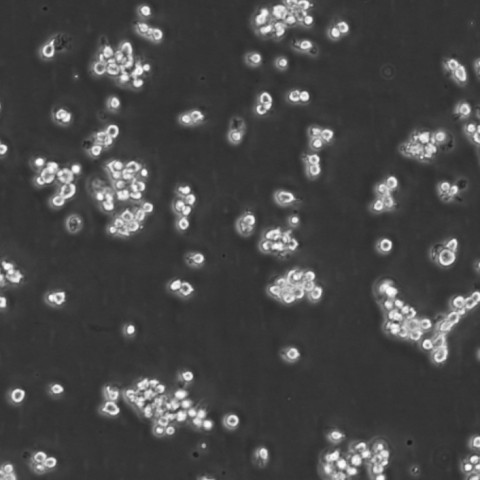
Ball 1 Cells人B淋巴细胞急性白血病可传代细胞系(送STR鉴定图谱)

"Ball 1 Cells人B淋巴细胞急性白血病可传代细胞系(送STR鉴定图谱)
形态特性:淋巴母细胞
生长特性:悬浮生长
背景信息:详见相关文献介绍
Ball 1 Cells人B淋巴细胞急性白血病可传代细胞系(送STR鉴定图谱)
┈订┈购(技术服务)┈热┈线:1┈3┈6┈4┈1┈9┈3┈0┈7┈9┈1【微信同号】┈Q┈Q:3┈1┈8┈0┈8┈0┈7┈3┈2┈4;
GM09737 Cells(提供STR鉴定图谱)
HAP1 BAZ2B (-) 4 Cells(提供STR鉴定图谱)
细胞的冻存:目前,细胞冻存Zui常用的技术是冷冻保存法,主要采用加适量保护剂的缓慢冷冻法冻存细胞。主要操作步骤为:(1)选择处于对数生长期的细胞,在冻存前一天ZuiHAO换。将多个培养瓶中的细胞培养去掉,用0.25%胰蛋白酶消化。适时去掉胰蛋白酶,加入少量新培养。用吸管吸取培养反复吹打瓶壁上的细胞,使其成为均匀分散的细胞悬。悬浮生产细胞则不要消化处理。然后将细胞收集于离心管中离心(1000r/min,10分钟)。(2)去上清,加入含20%小牛血清的完全培养基,于4℃预冷15分钟后,逐滴加入已无菌的DMSO或甘油,用吸管轻轻吹打使细胞均匀,细胞浓度为3×10(6)~1×10(7)/mL之间。(3)将上述细胞分装于安瓿或专用冷冻塑料管中,安瓿装1~1.5mL在火焰喷灯上封口,封口处要完全封闭,圆滑无勾。冷冻管要将盖子盖紧,并标记HAO细胞名称和冻存日期,同时作HAO登记(日期、细胞种类及代次、冻存支数)。(4)将装HAO细胞的安瓿或冻存管装入沙布袋内;置于容器颈口处存放过夜,次日转入中。采用控制降温速度的方法也可采用下列步骤:先将安瓿置入4℃冰箱中2~3小时,再移至冰箱冷冻室内3~4小时,再吊入容器颈气态部分存放2小时,Zui后沉入中。细胞冻存在中可以长期保存,但为妥善起见,冻存半年后,ZuiHAO取出一只安瓿细胞复苏培养,观察生长情况,然后再继续冻存。
HAP1 SNX17 (-) 2 Cells(提供STR鉴定图谱)
HG03167 Cells(提供STR鉴定图谱)
换液周期:每周2-3次
ATCC细胞库(American Type Culture Colection),该中心一直致力于细胞分类、鉴定和保藏工作。ATCC是全球最大的生物资源保藏中心,ATCC通过行业标准产品、服务和创新解决方案支持全球学术、政府、生物技术、制药、食品、农业和工业领域的科学进步。ATCC提供的服务和定制解决方案包括细胞和微生物培养、鉴定、生物衍生物的开发和生产、性能测试和生物资源保藏服务。美国国家标准协会(ANSI)认可了ATCC标准开发组织,并制定了标准协议,以确保生物材料的可靠性和可重复性。ATCC的使命是为了获取、鉴定、保存、开发、标准化和分发生物资源和生物信息,以提高和应用生物科学知识。
传代比例:1:2-1:4(首次传代建议1:2)
产品包装:复苏发货:T25培养瓶(一瓶)或冻存发货:1ml冻存管(两支)
Ball 1 Cells人B淋巴细胞急性白血病可传代细胞系(送STR鉴定图谱)
┈订┈购(技术服务)┈热┈线:1┈3┈6┈4┈1┈9┈3┈0┈7┈9┈1【微信同号】┈Q┈Q:3┈1┈8┈0┈8┈0┈7┈3┈2┈4;
来源说明:细胞主要来源ATCC、ECACC、DSMZ、RIKEN等细胞库
IBTCMi006-A Cells(提供STR鉴定图谱)
LM00008 Cells(提供STR鉴定图谱)
NCI-H1726 Cells(提供STR鉴定图谱)
PathHunter CHO-K1 mOPRD1 beta-arrestin Cells(提供STR鉴定图谱)
SA181 Cells(提供STR鉴定图谱)
物种来源:人源、鼠源等其它物种来源
冻存和复苏的原则:慢冻快融》当细胞冷到零度以下,可以产生以下变化:细胞器脱水,细胞中可溶性物质浓度升GAO,并在细胞内形成冰晶。如果缓慢冷冻,可使细胞逐步脱水,细胞内不致产生大的冰晶;相反,结晶就大,大结晶会造成细胞膜、纲胞器的损伤和破裂。复苏过程应快融,目的是防止小冰晶形成大冰晶,即冰晶的重结晶。慢冻程序》1.标准程序:采用细胞冻存器》当温度在-25℃以上时,1~2℃/min;当温度达-25℃以下时,5~10℃/min;当温度达-100℃时,可迅速放入中。2.简易程序:将冷冻管(管口要朝上)放入纱布袋内,纱布袋系以线绳,通过线绳将纱布袋固定于罐罐口,按每分钟温度下降1~2℃的速度,在40min内降至表面过夜,次晨投人中。3.传统程序:冷冻管置于4℃10分钟→-20℃30分钟→-80℃16~18小时(或隔夜)→槽长期储存。细胞冻存方法:1.预先配制冻存》(1)8%DMSO+细胞生长(92%血清)2.取对数生长期细胞,经胰酶消化后,加入适量冻存,用吸管吹打制成细胞悬(1×10(6)~5×10(6)细胞/ml)。3.加入1ml细胞于冻存管中,密封后标记冷冻细胞名称和冷冻日期。长期保存。保存细胞的复苏方法:1.快速解冻》冻存细胞从中取出后,立即放入37℃水浴中,轻轻摇动冷冻管,使其在1分钟内全部融化(不要超过3分钟)。2.解冻后的细胞可直接接种到含完全生长培养的细胞培养瓶中直接进行培养,24小时后再用新鲜完全培养替换旧培养,以去除DMSO。3.如果细胞对冷冻保护剂别敏感解冻后的细胞应先通过离心去除冷冻保护剂,然后再接种到含完全生长培养的培养瓶中。
108CC5-BU Cells(提供STR鉴定图谱)
Abcam HeLa ACHE KO Cells(提供STR鉴定图谱)
AG14149 Cells(提供STR鉴定图谱)
BayGenomics ES cell line RRD159 Cells(提供STR鉴定图谱)
BayGenomics ES cell line XF054 Cells(提供STR鉴定图谱)
BY00638 Cells(提供STR鉴定图谱)
CTAC Cells(提供STR鉴定图谱)
DA04674 Cells(提供STR鉴定图谱)
FPMI-CO-63 Cells(提供STR鉴定图谱)
Panc4.03 Cells;背景说明:详见相关文献介绍;传代方法:1:2传代;生长特性:贴壁生长;形态特性:上皮样;相关产品有:RMG-1细胞、EB2细胞、Melanoma 14细胞
SW-1990 Cells;背景说明:胰腺癌;男性;传代方法:1:2-1:3传代;每周换液2-3次。;生长特性:贴壁;形态特性:详见产品说明书;相关产品有:H-2342细胞、NB19-RIKEN细胞、SKNEP细胞
32D.3 Cells;背景说明:骨髓淋巴瘤;C3H/HeJ;传代方法:1:2-1:3传代;每周换液2-3次。;生长特性:悬浮;形态特性:详见产品说明书;相关产品有:TKB-1细胞、Hs 636.T细胞、Capan1细胞
WM-239 Cells;背景说明:黑色素瘤;女性;传代方法:1:2-1:3传代;每周换液2-3次。;生长特性:贴壁;形态特性:详见产品说明书;相关产品有:C8D1A细胞、Kit 225-K6细胞、2PK3细胞
K-562 Cells;背景说明:详见相关文献介绍;传代方法:1:2-1:3传代;每周换液2-3次。;生长特性:贴壁或悬浮,详见产品说明书部分;形态特性:详见产品说明书;相关产品有:GFP-Olig2细胞、Colo205细胞、H3255细胞
RC13 Cells;背景说明:肺泡横纹肌肉瘤;骨髓转移;传代方法:1:2-1:3传代;每周换液2-3次。;生长特性:贴壁;形态特性:详见产品说明书;相关产品有:JF305细胞、BE2-C细胞、HSC5细胞
NCI-H102 Cells;背景说明:详见相关文献介绍;传代方法:1:3传代,2-3天传一代;生长特性:悬浮生长 ;形态特性:圆形;淋巴母细胞样;相关产品有:KHYG1细胞、B/C3T3细胞、WIL2 S细胞
Jurkat Cells;背景说明:该细胞源自一位14岁患有T淋巴细胞白血病男性的外周血;传代方法:保持细胞密度在3—9×105cells/ml之间,1:5—1:10传代,每周换液2—3次;生长特性:悬浮生长;形态特性:圆形,单个或呈片;相关产品有:Pt-K1细胞、ACC2细胞、mRMEC细胞
HLE-SRA-01/04 Cells;背景说明:晶状体;上皮细胞;SV40转化;男性;传代方法:1:2-1:3传代;每周换液2-3次。;生长特性:贴壁;形态特性:详见产品说明书;相关产品有:Panc2.03细胞、CEMC7细胞、NTera 2细胞
CL1.0 Cells;背景说明:肺癌;男性;传代方法:1:2-1:3传代;每周换液2-3次。;生长特性:贴壁;形态特性:详见产品说明书;相关产品有:COR-L 105细胞、M14-MEL细胞、MMAc-Serum Free细胞
DoTc2 Cells;背景说明:详见相关文献介绍;传代方法:1:2—1:3传代,每周换液2—3次;生长特性:贴壁生长 ;形态特性:上皮样;相关产品有:Hs 688(A).T细胞、FU-OV-1细胞、MV4:11细胞
Hs-343-T Cells;背景说明:详见相关文献介绍;传代方法:1:2—1:3传代;每周换液2-3次。;生长特性:贴壁生长;形态特性:成纤维细胞;相关产品有:FL83B细胞、RCK-8细胞、HCT FET细胞
Hs 606 Cells;背景说明:详见相关文献介绍;传代方法:1:2—1:3传代,2—3天换液一次;生长特性:贴壁生长;形态特性:成纤维细胞;相关产品有:L132细胞、NCI-H2081细胞、NTERA-2 clone D1细胞
DoTc2 Cells;背景说明:详见相关文献介绍;传代方法:1:2—1:3传代,每周换液2—3次;生长特性:贴壁生长 ;形态特性:上皮样;相关产品有:Hs 688(A).T细胞、FU-OV-1细胞、MV4:11细胞
P30OHK Cells;背景说明:详见相关文献介绍;传代方法:10^5 cells/60mm dish;生长特性:悬浮生长;形态特性:淋巴母细胞;相关产品有:Rat-2细胞、H-4-II-E细胞、SK-MEL-5细胞
NL20 Cells;背景说明:支气管上皮细胞;SV40转化;女性;传代方法:1:2-1:3传代;每周换液2-3次。;生长特性:贴壁;形态特性:详见产品说明书;相关产品有:RIN m5F细胞、MLFC细胞、LTEP-sm 1细胞
NL20 Cells;背景说明:支气管上皮细胞;SV40转化;女性;传代方法:1:2-1:3传代;每周换液2-3次。;生长特性:贴壁;形态特性:详见产品说明书;相关产品有:RIN m5F细胞、MLFC细胞、LTEP-sm 1细胞
GM 637 Cells;背景说明:详见相关文献介绍;传代方法:1:2-1:3传代;每周换液2-3次。;生长特性:贴壁或悬浮,详见产品说明书部分;形态特性:详见产品说明书;相关产品有:TALL 1细胞、MV-1-Lu细胞、HCT15细胞
PaCa2 Cells;背景说明:详见相关文献介绍;传代方法:1:2传代;;生长特性:贴壁生长;形态特性:详见产品说明书;相关产品有:NTera-2D1细胞、118MG细胞、OCILY19细胞
OUMS-23 Cells;背景说明:详见相关文献介绍;传代方法:1:2-1:3传代;每周换液2-3次。;生长特性:贴壁或悬浮,详见产品说明书部分;形态特性:详见产品说明书;相关产品有:210RCY3-Ag1.2.3细胞、SF 763细胞、COLO206F细胞
KMY1022 Cells;背景说明:B淋巴细胞;EBV转化;传代方法:1:2-1:3传代;每周换液2-3次。;生长特性:悬浮;形态特性:详见产品说明书;相关产品有:OCILY-19细胞、CT26.CL25细胞、HCC0095细胞
AN3 CA Cells;背景说明:AN3CA细胞建系于1964年。它衍生于子宫内膜癌患者淋巴结转移组织,具有癌细胞的基本特性,能在体外长期传代培养,接种实验动物产生明显肿瘤。但细胞的生物学特性及超微结构尚未深入研究,仅发现该细胞系促黑激素合成为阴性。细胞常用于人子宫内膜癌细胞生物学及其相关特性研究。;传代方法:1:2传代;生长特性:贴壁生长;形态特性:上皮样;相关产品有:BV-2细胞、Ishikawa细胞、COLO 679细胞
MCF7-CTRL Cells;背景说明:MCF-7细胞保留了多个分化了的乳腺上皮的特性,包括:能通过胞质雌激素受体加工雌二醇并能形成圆形复合物(domes)。该细胞含有Tx-4癌基因。肿瘤坏死因子α(TNFalpha)可以抑制MCF-7细胞的生长。抗雌激素处理细胞能调变IGFBP'S的分泌。;传代方法:1:2传代,3-4天长满;生长特性:贴壁生长;形态特性:上皮样;相关产品有:SK HEP-1细胞、RS411细胞、Caco-2细胞
NK-92.05 Cells;背景说明:NK细胞;淋巴瘤;男性;传代方法:1:2-1:3传代;每周换液2-3次。;生长特性:悬浮;形态特性:详见产品说明书;相关产品有:32D-Cl3细胞、H1573细胞、NCI-H146细胞
Balb/3T3-4-Cl31 Cells;背景说明:胚胎;成纤维;自发永生;雄性;BALB/c;传代方法:1:2-1:3传代;每周换液2-3次。;生长特性:贴壁;形态特性:详见产品说明书;相关产品有:PL-5细胞、Tb1.Lu细胞、CHG5细胞
┈订┈购(技术服务)┈热┈线:1┈3┈6┈4┈1┈9┈3┈0┈7┈9┈1【微信同号】┈Q┈Q:3┈1┈8┈0┈8┈0┈7┈3┈2┈4;
Nb2a Cells;背景说明:详见相关文献介绍;传代方法:1:2-1:4传代;2-3天换液1次;生长特性:贴壁生长;形态特性:详见产品说明书;相关产品有:CEM clone 7细胞、PIGI细胞、Kato-III细胞
SLMT1 Cells;背景说明:详见相关文献介绍;传代方法:1:2-1:3传代;每周换液2-3次。;生长特性:贴壁或悬浮,详见产品说明书部分;形态特性:详见产品说明书;相关产品有:L 428细胞、SK-N-F1细胞、HEC-1-B细胞
C-26 Cells;背景说明:详见相关文献介绍;传代方法:1:2-1:3传代;每周换液2-3次。;生长特性:贴壁或悬浮,详见产品说明书部分;形态特性:详见产品说明书;相关产品有:NCI-SNU-878细胞、NS-1-Ag4-1细胞、J-774A.1细胞
Hs 832(C).T Cells;背景说明:卵巢,恶性囊肿;传代方法:1:2-1:3传代;每周换液2-3次。;生长特性:贴壁;形态特性:详见产品说明书;相关产品有:H-2085细胞、NW38细胞、HCC-202细胞
DR2R1610 Cells;背景说明:详见相关文献介绍;传代方法:1:2-1:3传代;每周换液2-3次。;生长特性:贴壁或悬浮,详见产品说明书部分;形态特性:详见产品说明书;相关产品有:253J细胞、50.B1细胞、Tregs细胞
Ball 1 Cells人B淋巴细胞急性白血病可传代细胞系(送STR鉴定图谱)
HIMEC Cells;背景说明:肠微血管内皮 Cells;传代方法:1:2-1:3传代;每周换液2-3次。;生长特性:贴壁;形态特性:详见产品说明书;相关产品有:NCI-157细胞、2V6.11细胞、SCL-2细胞
GM2132 Cells;背景说明:来源于一位61岁的男性浆细胞瘤患者;可产生免疫球蛋白轻链,未检测到重链。;传代方法:按1:2传代,5-6小时可以看到细胞分裂;生长特性:悬浮生长;形态特性:淋巴母细胞样;相关产品有:CCD 841 CoTr细胞、H2347细胞、WEHI-3细胞
H889 Cells;背景说明:详见相关文献介绍;传代方法:每周换液2-3次;生长特性:贴壁或悬浮,详见产品说明书部分;形态特性:上皮细胞;相关产品有:MDAMB415细胞、MDA.MB.435细胞、Ramos 2G6 4C10细胞
hTERT-HME-1 Cells;背景说明:详见相关文献介绍;传代方法:1:2-1:3传代;每周换液2-3次。;生长特性:贴壁或悬浮,详见产品说明书部分;形态特性:详见产品说明书;相关产品有:293-EBNA细胞、HGF-1细胞、KOPN-8细胞
BNL CL2 Cells;背景说明:详见相关文献介绍;传代方法:1:2传代;生长特性:贴壁生长 ;形态特性:详见产品说明书;相关产品有:BT 20细胞、MDA2B细胞、Hs-600-T细胞
NCI-H2228 Cells;背景说明:详见相关文献介绍;传代方法:1:2-1:3传代,每周2-3次。;生长特性:贴壁生长;形态特性:详见产品说明书;相关产品有:HEM细胞、CaES-17细胞、Jiyoye(P-2003)细胞
SW780 Cells;背景说明:详见相关文献介绍;传代方法:1:2-1:3传代;每周换液2-3次。;生长特性:贴壁或悬浮,详见产品说明书部分;形态特性:详见产品说明书;相关产品有:TOV-21G细胞、EB3 [Human Burkitt lymphoma]细胞、Vero E6细胞
TMPi002-B Cells(提供STR鉴定图谱)
UD-SCC-1 Cells(提供STR鉴定图谱)
10C5.6 Cells(提供STR鉴定图谱)
SW780 Cells;背景说明:详见相关文献介绍;传代方法:1:2-1:3传代;每周换液2-3次。;生长特性:贴壁或悬浮,详见产品说明书部分;形态特性:详见产品说明书;相关产品有:TOV-21G细胞、EB3 [Human Burkitt lymphoma]细胞、Vero E6细胞
OC316 Cells;背景说明:详见相关文献介绍;传代方法:1:2-1:3传代;每周换液2-3次。;生长特性:贴壁或悬浮,详见产品说明书部分;形态特性:详见产品说明书;相关产品有:COLO320HSR细胞、WEHI-279细胞、Human Embryo Kidney-2细胞
NCIH1993 Cells;背景说明:详见相关文献介绍;传代方法:1:2—1:6传代;生长特性:贴壁或悬浮,详见产品说明书部分;形态特性:详见产品说明书;相关产品有:3AA细胞、KPL4细胞、HUV-EC-C细胞
NS20-Y Cells;背景说明:神经母细胞瘤;雄性;A/J;传代方法:1:2-1:3传代;每周换液2-3次。;生长特性:贴壁;形态特性:详见产品说明书;相关产品有:F442-A细胞、HeLa229细胞、FM-88细胞
6-10B Cells;背景说明:鼻咽癌;传代方法:1:2-1:3传代;每周换液2-3次。;生长特性:贴壁;形态特性:详见产品说明书;相关产品有:SK-ChA-1细胞、OVCA8细胞、SU-86-86细胞
DK-MG Cells;背景说明:胶质母细胞瘤;女性;传代方法:1:2-1:3传代;每周换液2-3次。;生长特性:贴壁;形态特性:详见产品说明书;相关产品有:CAL-12T细胞、NRCC细胞、OCI-LY-18细胞
CHP 126 Cells;背景说明:详见相关文献介绍;传代方法:1:2-1:3传代;每周换液2-3次。;生长特性:贴壁或悬浮,详见产品说明书部分;形态特性:详见产品说明书;相关产品有:H-23细胞、OVCAR.3细胞、Cates-1B细胞
Panc 02 Cells;背景说明:详见相关文献介绍;传代方法:1:2传代;生长特性:贴壁生长 ;形态特性:详见产品说明书;相关产品有:T47-D细胞、Hs675T细胞、Pan02细胞
Hx-147 Cells;背景说明:详见相关文献介绍;传代方法:1:2-1:3传代;每周换液2-3次。;生长特性:贴壁或悬浮,详见产品说明书部分;形态特性:详见产品说明书;相关产品有:PLB 985细胞、MES-23.5细胞、PG-4细胞
KYSE180 Cells;背景说明:食管鳞癌;男性;传代方法:1:2-1:3传代;每周换液2-3次。;生长特性:贴壁;形态特性:详见产品说明书;相关产品有:RSC-96细胞、SU4细胞、JROECL21细胞
NP-69 Cells;背景说明:鼻咽;上皮细胞;SV40转化;传代方法:1:2-1:3传代;每周换液2-3次。;生长特性:贴壁;形态特性:详见产品说明书;相关产品有:H-4-II-E细胞、Huh7.5细胞、NCIH1105细胞
CEMO-1 Cells;背景说明:急性B淋巴细胞白血病;男性;传代方法:1:2-1:3传代;每周换液2-3次。;生长特性:悬浮;形态特性:详见产品说明书;相关产品有:HCC-1395细胞、MADB 106细胞、NUGC-3细胞
EFO 27 Cells;背景说明:详见相关文献介绍;传代方法:1:2-1:3传代;每周换液2-3次。;生长特性:贴壁或悬浮,详见产品说明书部分;形态特性:详见产品说明书;相关产品有:TU 686细胞、Kit-225细胞、JB6 [Mouse]细胞
H9 Cells;背景说明:H9细胞是HUT78(ATCCTIB161)的克隆系(Callo,RC,etal)。细胞表面带有CD3、CD4标记。研究表明,该细胞系对人体免疫缺陷病毒(HIV-1)敏感,可用于检测、分离和增殖HIV-1,也可用于其它人类Tcell病毒的研究。;传代方法:1:3传代,2-3天传一代;生长特性:悬浮生长;形态特性:淋巴母细胞样;相关产品有:8402细胞、TE-10细胞、HEK 293细胞
FAT Cells;背景说明:鼻咽癌;传代方法:1:2-1:3传代;每周换液2-3次。;生长特性:贴壁;形态特性:详见产品说明书;相关产品有:Dunn LM8细胞、IPLB-SF 21AE细胞、H1650_CO细胞
HFF-1 Cells;背景说明:详见相关文献介绍;传代方法:1:5-1:7传代;生长特性:贴壁生长;形态特性:成纤维细胞;相关产品有:MHCC 97-L细胞、McARH7777细胞、HCC827细胞
HIMEC Cells;背景说明:肠微血管内皮 Cells;传代方法:1:2-1:3传代;每周换液2-3次。;生长特性:贴壁;形态特性:详见产品说明书;相关产品有:NCI-157细胞、2V6.11细胞、SCL-2细胞
CWR-22rv1 Cells;背景说明:22RV1是来自异种移植(在阉割引起前列腺癌衰退又在其父亲的雄性激素信赖型CWR22嫁接后复发的小鼠中连续传代)的人前列腺癌上皮细胞系。此细胞系表达前列腺特异抗原。二羟基睾丸脂酮轻微刺激细胞生长,经westernblot检测溶解产物与抗雄性激素受体抗体起免疫反应。EGF刺激细胞生长,但TGFβ-1不能抑制细胞生长。该细胞在裸鼠中成瘤。;传代方法:消化3-5分钟。1:2。3天内可长满。;生长特性:贴壁生长;形态特性:上皮细胞;相关产品有:H-929细胞、Hs 606细胞、DF-1细胞
Adeno-293 Cells;背景说明:详见相关文献介绍;传代方法:1:2传代;生长特性:贴壁生长;形态特性:详见产品说明书;相关产品有:VMRC-LCD细胞、TSCC1细胞、8402细胞
Adeno-293 Cells;背景说明:详见相关文献介绍;传代方法:1:2传代;生长特性:贴壁生长;形态特性:详见产品说明书;相关产品有:VMRC-LCD细胞、TSCC1细胞、8402细胞
HL 60 Cells;背景说明:该细胞由CollinsSJ从一位患有急性早幼粒细胞性白血病的36岁白人女性的外周血中分离建立;可自发分化,或在盐、次黄嘌呤、佛波醇肉豆蔻酸(PMA,TPA)、DMSO(1%to1.5%)、D和视黄酸的刺激下发生分化;PMA刺激后可分泌TNF-α。该细胞具有吞噬活性和趋化反应,癌基因myc阳性,表达补体受体和FcR。;传代方法:维持细胞浓度在1×105-1×106/ml,每2-3天换液1次。;生长特性:悬浮生长;形态特性:髓母细胞样;相关产品有:SW 948细胞、B-104细胞、RERFLCMS细胞
Colo-678 Cells;背景说明:详见相关文献介绍;传代方法:1:2-1:3传代;每周换液2-3次。;生长特性:贴壁或悬浮,详见产品说明书部分;形态特性:详见产品说明书;相关产品有:SupB15WT细胞、Hela-mock细胞、Biopsy xenograft of Pancreatic Carcinoma line-3细胞
Capan2 Cells;背景说明:详见相关文献介绍;传代方法:1:2-1:4传代,2-3天换液1次。;生长特性:贴壁生长;形态特性:多边形;相关产品有:H-460细胞、KMB 17细胞、DI TNC1细胞
SKG-3a Cells;背景说明:详见相关文献介绍;传代方法:2x10^4 cells/ml;生长特性:贴壁生长;形态特性:上皮细胞样;相关产品有:TALL1细胞、NIT-1细胞、Hs 604.T细胞
KLM-1 Cells;背景说明:详见相关文献介绍;传代方法:1:2-1:3传代;每周换液2-3次。;生长特性:贴壁或悬浮,详见产品说明书部分;形态特性:详见产品说明书;相关产品有:RPE1细胞、KALS1细胞、MEL细胞
Hca-F Cells;背景说明:肝癌;传代方法:1:2-1:3传代;每周换液2-3次。;生长特性:贴壁;形态特性:详见产品说明书;相关产品有:ARO81细胞、RASMCs细胞、SK Mel 2细胞
NCI-H838 Cells;背景说明:该细胞于1984年建系,源于一位59岁患有非小细胞肺癌的白人男性吸烟者,从患者淋巴结转移灶分离而来。;传代方法:1:3-1:6传代;2-3天换液1次。;生长特性:贴壁生长;形态特性:上皮样;相关产品有:hTERT-RPE-1细胞、R1610细胞、Okayama University Medical School-23细胞
22Rv1 Cells;背景说明:22RV1是来自异种移植(在阉割引起前列腺癌衰退又在其父亲的雄性激素信赖型CWR22嫁接后复发的小鼠中连续传代)的人前列腺癌上皮细胞系。此细胞系表达前列腺特异抗原。二羟基睾丸脂酮轻微刺激细胞生长,经westernblot检测溶解产物与抗雄性激素受体抗体起免疫反应。EGF刺激细胞生长,但TGFβ-1不能抑制细胞生长。该细胞在裸鼠中成瘤。;传代方法:消化3-5分钟。1:2。3天内可长满。;生长特性:贴壁生长;形态特性:上皮细胞;相关产品有:MDA.MB.231细胞、GM04680细胞、UT-7细胞
┈订┈购(技术服务)┈热┈线:1┈3┈6┈4┈1┈9┈3┈0┈7┈9┈1【微信同号】┈Q┈Q:3┈1┈8┈0┈8┈0┈7┈3┈2┈4;
RBL-I Cells;背景说明:详见相关文献介绍;传代方法:1:2-1:3传代;每周换液2-3次。;生长特性:贴壁或悬浮,详见产品说明书部分;形态特性:详见产品说明书;相关产品有:PFSK1细胞、B16细胞、Institute for Medical Research-32细胞
H-548 Cells;背景说明:详见相关文献介绍;传代方法:1:2-1:3传代;每周换液2-3次。;生长特性:贴壁或悬浮,详见产品说明书部分;形态特性:详见产品说明书;相关产品有:HHL-5细胞、BMSC/hBMSCs细胞、HR8348细胞
CCRFCEM Cells;背景说明:G.E. Foley 等人建立了类淋巴母细胞细胞株CCRF-CEM。 细胞是1964年11月从一位四岁白人女性急性淋巴细胞白血病患者的外周血白血球衣中得到。此细胞系从香港收集而来。;传代方法:1:2传代。3天内可长满。;生长特性:悬浮生长;形态特性:淋巴母细胞样;相关产品有:MM-1S细胞、SR786细胞、HTori:3细胞
SNU368 Cells;背景说明:详见相关文献介绍;传代方法:1:2传代;生长特性:贴壁生长;形态特性:上皮细胞样;相关产品有:NB-4细胞、GM02219细胞、Detroit562细胞
NCI-H1694 Cells;背景说明:详见相关文献介绍;传代方法:3-4天换液1次。;生长特性:悬浮生长;形态特性:聚团悬浮;相关产品有:H1048细胞、OKAC1细胞、NCI-H441细胞
HCT-GEO Cells;背景说明:结肠癌;传代方法:1:2-1:3传代;每周换液2-3次。;生长特性:贴壁;形态特性:详见产品说明书;相关产品有:SF 126细胞、MFE-296细胞、MM1细胞
H-1793 Cells;背景说明:详见相关文献介绍;传代方法:1:3-1:6传代 ;生长特性:贴壁生长;形态特性:上皮细胞;相关产品有:ECC-10细胞、DU_145细胞、JEG3细胞
A-172MG Cells;背景说明:详见相关文献介绍;传代方法:1:2-1:3传代;每周换液2-3次。;生长特性:贴壁或悬浮,详见产品说明书部分;形态特性:详见产品说明书;相关产品有:HLEpiC细胞、IPLB-Sf21-AE细胞、H-378细胞
HeLa-229 Cells;背景说明:宫颈癌;女性;传代方法:1:2-1:3传代;每周换液2-3次。;生长特性:贴壁;形态特性:详见产品说明书;相关产品有:Hs729T细胞、SKNF1细胞、SCC 15细胞
NCI-H2196 Cells;背景说明:详见相关文献介绍;传代方法:1:3-1:6传代;每周换液2次。;生长特性:贴壁或悬浮,详见产品说明书部分;形态特性:详见产品说明书;相关产品有:ARH-77细胞、NCM460细胞、SW 1353细胞
Ball 1 Cells人B淋巴细胞急性白血病可传代细胞系(送STR鉴定图谱)
BayGenomics ES cell line CSD021 Cells(提供STR鉴定图谱)
BayGenomics ES cell line RRS702 Cells(提供STR鉴定图谱)
BayGenomics ES cell line YTC109 Cells(提供STR鉴定图谱)
IMM010.109.12 Cells(提供STR鉴定图谱)
PCRP-SIRT2-1A2 Cells(提供STR鉴定图谱)
LERS-1 Cells(提供STR鉴定图谱)
"